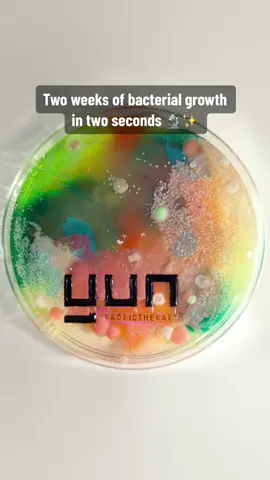
Life of microscopic pets 🤭 #bacteria #mold #molds #fungi #agar #agarart #zoomchallenge #closeup #microscope #microscopic #microscopic #yunprobiotherapy #yunskincare #probiotics #bacterial #bacteriën #bacterien #microbe #microbes #Science #bioscience #biology

Kill Bill
Region: US
Friday 01 April 2022 15:59:32 GMT
2014786
197976
1485
4604
Music
Download
Comments
user7742784499111 :
Bro be so goofy sometimes
2022-04-01 16:08:56
8539
UMBHADAMI :
Nabu ubunkunzi😂
2025-11-15 20:46:04
0
Braydon brown :
My name Kodak black but when u see I’m whiteeeee
2022-04-01 16:12:31
4828
Kethangg :
Is this actually his account 😂
2022-04-01 16:11:04
857
playingthebackseat :
Yak x Ed Sheeran Collab 👀👀
2022-04-01 16:02:27
4205
D E $ T I N Y 🐐 :
2025 😂
2025-09-22 09:23:14
14
Kenny💰 :
this duo gone b hard asl😭🔥
2022-04-01 16:09:16
1037
GABRIEL ♰ :
Thats about a man 💔
2025-10-18 13:07:29
0
J Weezy :
unfortunately that's a hit
2022-04-01 16:10:18
1673
🧟♂️ :
I'm in luh widda shapuh yu
2025-02-26 16:30:51
4
Therealyungjay :
My name Kodak black but when u see me I'm white
2022-04-01 16:46:44
596
ck :
can you say your thoughts on the island boys
2022-04-01 16:06:57
2
micah :
kodak sheeran
2022-04-01 16:08:43
364
Howard :
They really trying to troll Kodak w “story time” and “crop”😭
2022-04-01 16:29:54
656
monkeydickcum :
Yoooo
2022-04-01 16:07:30
3
Veeeee :
why you be postin
2022-04-01 16:08:57
14
Anderson Mcflanigan :
Kodak x Sheeran collar album?
2022-04-13 20:58:30
1
urfavblackbarbie06 :
The caption is so real 😭😭
2025-06-09 15:36:14
2
Andrew Mcclellan :
He just trollin now
2022-04-01 16:07:27
3
To see more videos from user @kodakblack, please go to the Tikwm
homepage.